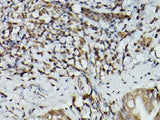
TFEB Polyclonal Antibody

TFEB Polyclonal Antibody
SKU: E-AB-93321-200
TFEB Polyclonal Antibody
| SKU # | E-AB-93321 |
| Reactivity | Human, Mouse, Rat |
| Host | Rabbit |
| Applications | WB, IHC, IF |
Product Details
| Isotype | IgG |
| Host | Rabbit |
| Reactivity | Human, Mouse, Rat |
| Applications | WB, IHC, IF |
| Clonality | Polyclonal |
| Immunogen | Recombinant fusion protein of human TFEB |
| Abbre | TFEB |
| Synonyms | ALPHATFEB, BHLHE35, TCFEB, TFEB |
| Swissprot | |
| Calculated MW | 53 kDa/54 kDa/55 kDa |
| Observed MW | Refer to figures |
| Cellular Localization | Mitochondrion, Mitochondrion inner membrane, Mitochondrion matrix, mitochondrion nucleoid. |
| Concentration | 1 mg/mL |
| Buffer | Phosphate buffered solution, pH 7.4, containing 0.05% stabilizer and 50% glycerol. |
| Purification Method | Affinity purification |
| Research Areas | Cancer, Metabolism, Signal Transduction |
| Conjugation | Unconjugated |
| Storage | Store at -20°C Valid for 12 months. Avoid freeze / thaw cycles. |
| Shipping | The product is shipped with ice pack,upon receipt,store it immediately at the temperature recommended. |
Related Reagents
| Applications | Recommended Dilution |
| WB | 1:500-1:2000 |
| IHC | 1:50-1:200 |
| IF | 1:50-1:200 |
Background
This gene encodes a protein which is a member of the cysteine-aspartic acid protease (caspase) family. Sequential activation of caspases plays a central role in the execution-phase of cell apoptosis. Caspases exist as inactive proenzymes which undergo proteolytic processing at conserved aspartic residues to produce 2 subunits, large and small, that dimerize to form the active enzyme. This gene was identified by its ability to proteolytically cleave and activate the inactive precursor of interleukin-1, a cytokine involved in the processes such as inflammation, septic shock, and wound healing. This gene has been shown to induce cell apoptosis and may function in various developmental stages. Studies of a similar gene in mouse suggest a role in the pathogenesis of Huntington disease. Alternative splicing results in transcript variants encoding distinct isoforms.